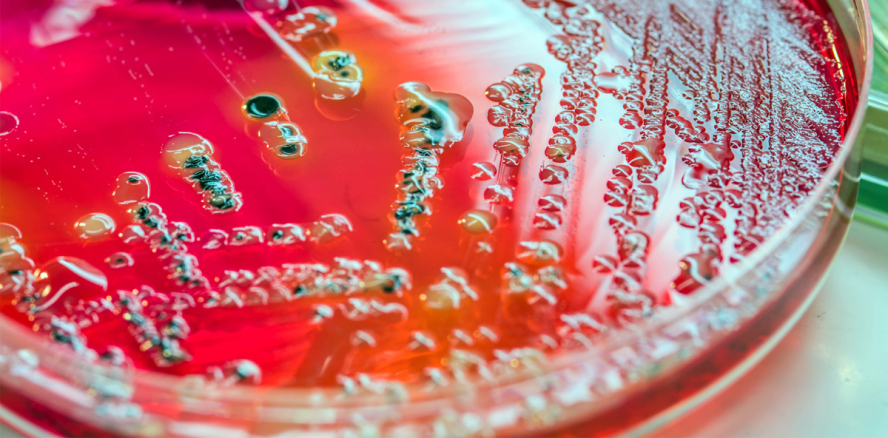
Mit Mikroben zur schnelleren Parodontitisdiagnose

Wissenschaft und Forschung 07.10.2016
Mit Mikroben zur schnelleren Parodontitisdiagnose
share
Fast 80 Prozent der über 35-Jährigen leiden unter Parodontitis, in ihrer schweren Form zählt sie mittlerweile zu den sechshäufigsten chronischen Erkrankungen weltweit. Als Vorstufe bzw. Vorbote gilt oft die Gingivitis. Beide Erkrankungen unterscheiden sich nicht nur in ihren Symptomen, sondern auch in der mikrobiellen Zusammensetzung. Das fanden jetzt Forscher bei der Untersuchung von annähernd 1.000 malawischen Frauen heraus, die damit einen Grundstein für eine schnellere Parodontitisdiagnose gelegt haben.
Ihre Forschungsergebnisse veröffentlichten die Wissenschaftler rund um den Briten Liam Shaw jüngst im Applied and Environmental Microbiology, einer Publikation der American Society for Microbiology. Um das mikrobielle Klima in der Mundhöhle bei Gingivitis und Parodontitis zu differenzieren, erstellten die Forscher mithilfe der Hochgeschwindigkeits-Sequenzierung der 16S ribosomalen RNA einen Zensus der oralen Mikroben. Dabei fanden sie eine kleine Anzahl an Spezies, die in Verbindung mit Parodontitis aber nicht mit Gingivitis gebracht werden, unter ihnen die Gattungen Prevotella, Treponema und Selemonas.
Normalerweise wird Parodontitis anhand der Taschentiefe diagnostiziert bzw. dann, wenn die ersten Zähne beweglich sind, was oft zu spät ist, um der Entzündung entgegenzuwirken. Zudem erfordert die Diagnose Expertenwissen und teures Equipment, was gerade in unterentwickelten Ländern nicht immer verfügbar ist. Doch auch in den Industrienationen ist Parodontitis ein großes Problem, was sich nicht allein anhand von Zahnfleischbluten diagnostizieren lässt, da die Blutungen auch viele andere Ursachen haben können.
Mit ihrer Studie haben die Wissenschaftler den Grundstein gelegt, um eine schnelle und preiswerte Diagnose stellen und bei Parodontitis frühzeitig gegensteuern zu können.
Ein Abstract der Studie gibt es hier.
Quelle: American Society for Microbiology